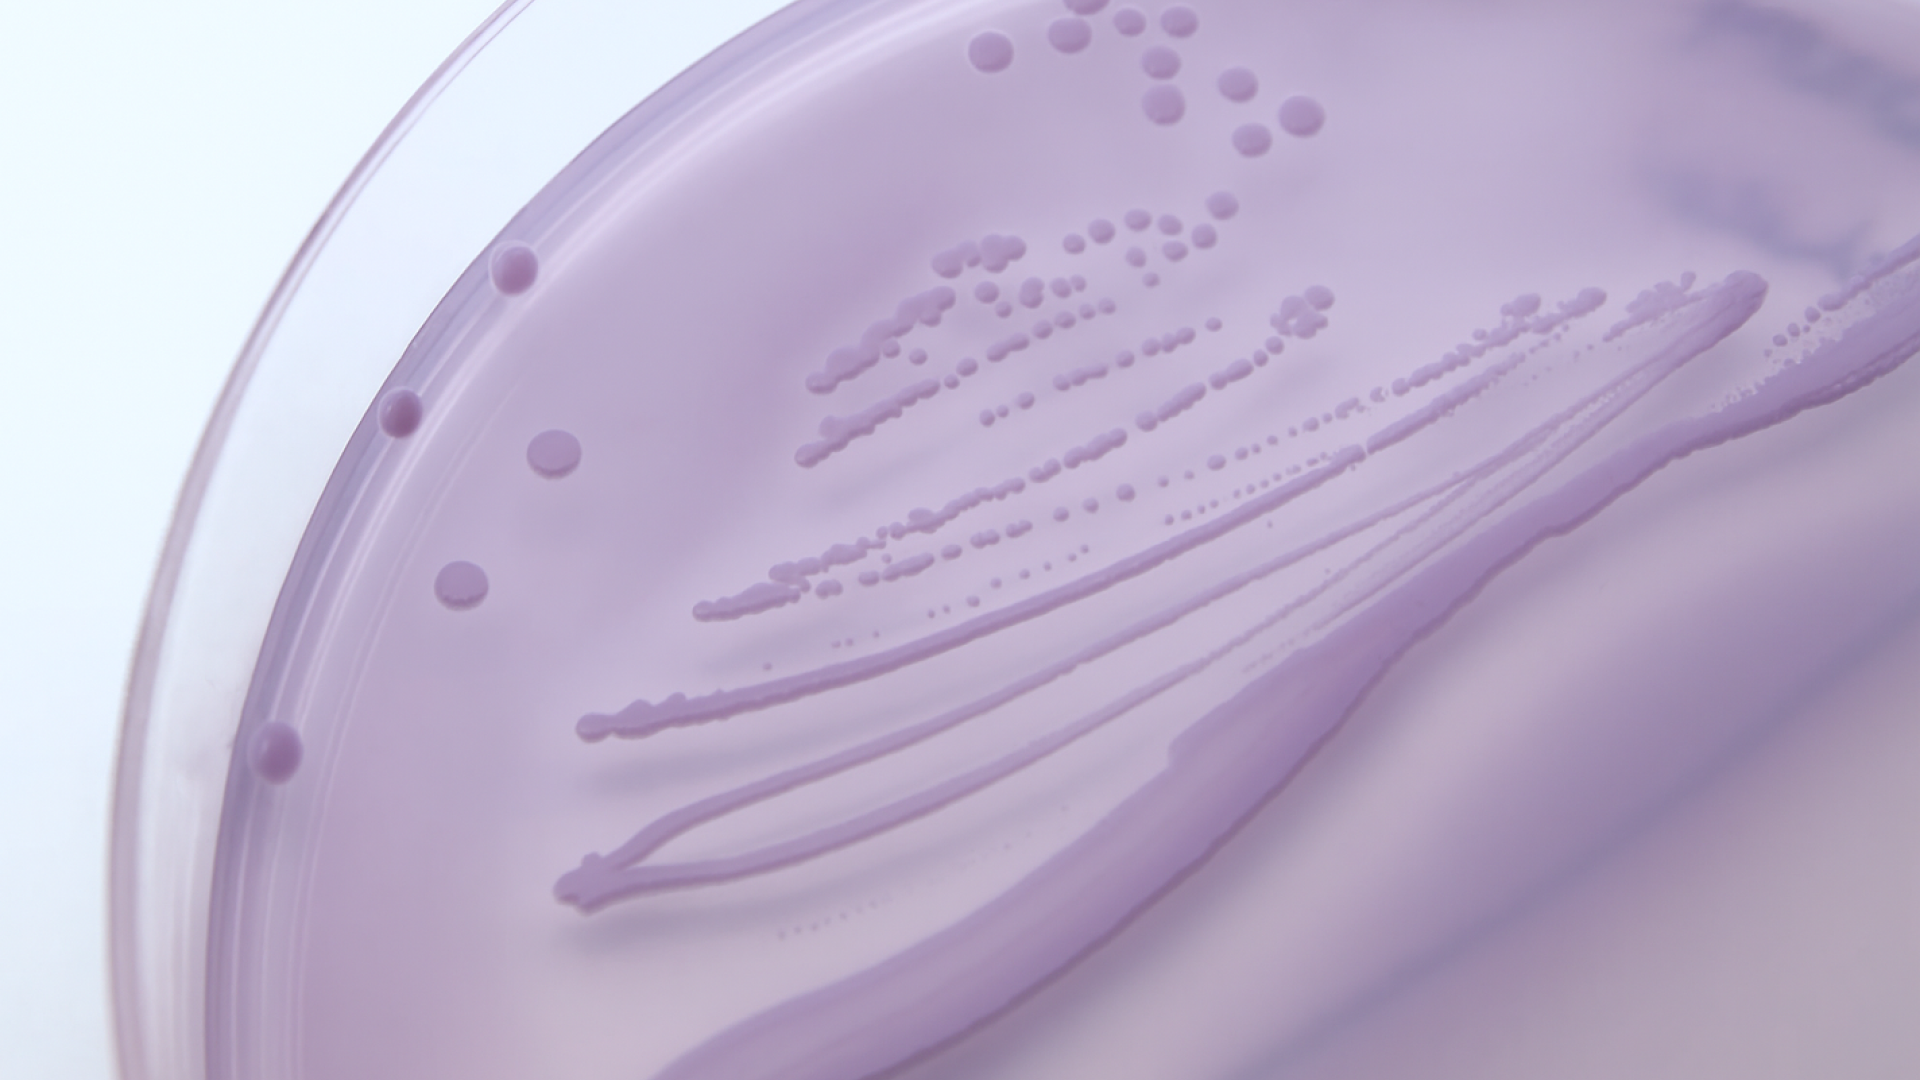

Like any at-home illness or infection test kit, there are myths surrounding the accuracy of urinary tract infection (UTI) screening tests that you administer yourself – namely, that they don’t work. In reality, though, this couldn’t be further from the truth.
Not only are UTI test kit results collected at home accurate, but they’re no different from the UTI tests initially administered by a doctor when a UTI is suspected.
For peace of mind when self-testing for a UTI at home, there are a handful of things you should know. Let’s explore some of the most common questions about testing yourself for a UTI, including a deep dive into their accuracy and why the Health Alert Urinary Tract Infection Screening Kit is the best at-home solution on the market.
How do home UTI kits work?
Self-test UTI kits administered at home work by measuring the levels of nitrites and leukocytes present in your urine.
Nitrites occur when nitrates, which are always found in the urine in small amounts, are chemically altered by the existence of UTI-causing bacteria.
Leukocytes indicate an infection or inflammatory response in the bladder. While these can be present because of other infections, too – such as sexually transmitted infections (STIs) or kidney infections – the most common cause of elevated leukocyte levels in urine is a UTI.
How accurate are home UTI tests?
It’s a common question: can you trust UTI tests at home? Well, the answer is a resounding yes.
Health Alert’s Urinary Tract Infection Screening Kit offers 99% accuracy, which means the margin for error is very small. If administered correctly by following the provided instructions, you’re almost guaranteed to receive an accurate result.
However, it’s important to note that this may differ based on your choice of at-home UTI screening kit – some tests may not be as accurate as Health Alert’s. There are also several external factors that can limit the accuracy of UTI tests administered at home.
What factors can impact home UTI test accuracy?
At-home UTI tests like Health Alert’s are 99% accurate when there are no limiting external factors present – however, certain stressors can cause a false or inconclusive result.
These include:
● The medications and supplements you take: There are several medications and vitamins that can impact the accuracy of any UTI test, such as vitamin C, multivitamins, acetazolamide, potassium citrate, sodium bicarbonate, nitrofurantoin, or anything formulated with azo dyes.
● The bacteria causing your UTI: If your UTI is caused by an uncommon bacteria that doesn’t work by converting nitrates into nitrates, it’s likely you’ll receive an inconclusive or false result when using an at-home UTI test.
● The foods you eat: Nitrates are found naturally in many vegetables and some meats, but not everyone eats these kinds of foods. If nitrates aren’t present in your diet, they won’t be in your urine, rendering an at-home UTI test ineffective for you. You’ll need to see a doctor and request a non-nitrate-based test to confirm whether you have a UTI.
● How long your urine has been in your bladder: If the urine you use to administer your test hasn’t been held in your bladder for 4 hours or more, this can lead to a false or inaccurate result on an at-home UTI test.
UTI test comparison: At-home tests vs seeing a doctor
If you’re weighing up whether to trust an at-home UTI test or to see a doctor, consider this comparison between the two:
At-home tests:
● Can be purchased in-store or online
● Deliver results within 2 minutes
● Are easy and convenient to administer yourself
● Can be taken from the comfort of your home
● Cost just $14.99 (RRP)
● Are 99% accurate
● May be impacted by uncontrollable external factors like medication
● Can provide inconclusive or false results in <1% of cases
Tests at a doctor’s office:
● Require making, attending, and following up an appointment
● Can take weeks for results to be received
● Must be administered by a healthcare professional
● Can cost upwards of $50, depending on your GP’s pricing and billing options
● May be impacted by uncontrollable external factors like medication
● Can provide inconclusive or false results in up to 50% of cases if using a dipstick test
● Can be conducted multiple ways and times to ensure better accuracy
While doctor’s tests can be more accurate than an at-home test in the long run, this goes beyond the preliminary test you’ll receive, which on most occasions will be a dipstick test. Dipstick tests have been criticised for their poor accuracy, which means more follow-up tests are necessary – usually with added costs.
If you think you may have a UTI and are looking to confirm your suspicions, an at-home test can help you do that without having to visit the doctor’s.
What happens if my UTI test results are wrong?
If you’ve used an at-home UTI test like the Health Alert Urinary Tract Infection Screening Test Kit and fear your results may be wrong, the best thing to do is to visit a GP or healthcare practitioner to receive a more comprehensive follow-up test.
Doctors can administer a more in-depth UTI test, such as a urine culture test, a cystoscopy, or a blood test. A comprehensive medical analysis is the only way to determine whether you have a UTI with 100% certainty.
The most reliable UTI test on the market
While the accuracy of over-the-counter UTI tests is never 100%, Health Alert’s Urinary Tract Infection Screening Test Kit is as close as you can get to certainty without having to visit a doctor.
Ours is the most reliable home UTI test available in Australia, making it the perfect choice for those who think they may have a UTI but want peace of mind before seeking treatment.
Whether you’re currently dealing with a suspected UTI or just want to stock up for the future, shop the Health Alert Urinary Tract Infection Screening Kit now, and enjoy flat-rate shipping across Australia.